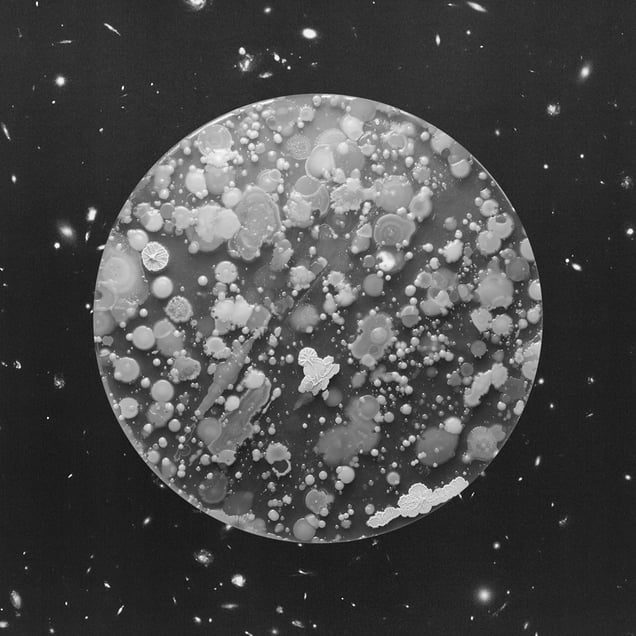
Tire

Photos (26)

File:
Bank Terminal.jpg

File:
Bar Seat.jpg

File:
Billiard Pool.jpg

File:
Bus Handrail.jpg

File:
Cat.jpg

File:
Church Step.jpg

File:
Dog.jpg

File:
Fastfood Tray.jpg

File:
Grass.jpg

File:
Keys.jpg

File:
Laptop.jpg
Cover

File:
Mobile.jpg

File:
Money.jpg

File:
Old Book.jpg

File:
Petrol Pump.jpg

File:
Pizza.jpg

File:
Playing Cards.jpg

File:
Pub Glass.jpg

File:
Ringbell.jpg

File:
River.jpg

File:
Square Statue.jpg

File:
Stranger Hand.jpg
File:
Tire.jpg

File:
Toothbrush.jpg

File:
Undershoe.jpg

File:
Women Toilet.jpg
Add To Collection
No photos
Collaborated
